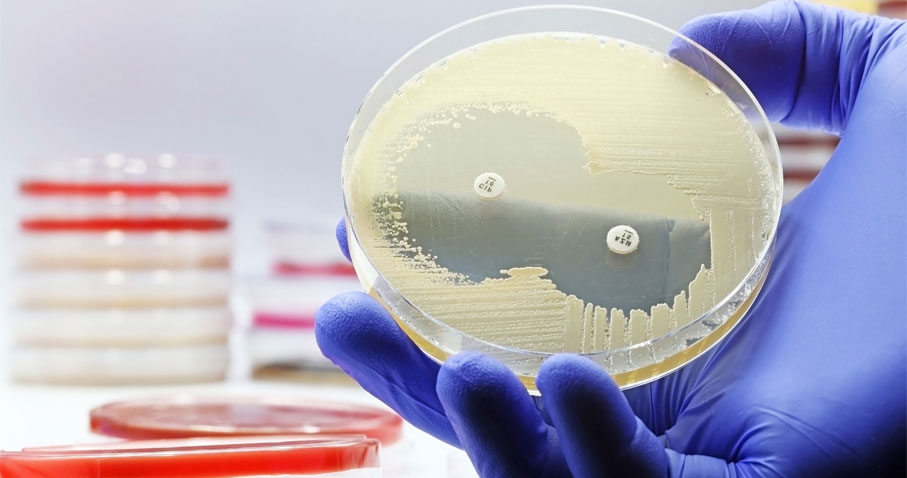

-
BD Sensi-Disc™ Moxifloxacin MXF-5, 10 Ea
SKU/REF 295308
-
BD Sensi-Disc™ Fosfomycin FOS-200, 10 Ea
SKU/REF 295306
-
BD Sensi-Disc™ Doripenem, 10 Ea
SKU/REF 232219
-
BD Sensi-Disc™ Ceftazidime/Avibactam CAZ-AVI
SKU/REF 232218
-
BD Sensi-Disc™ Tigecycline TGC-15, 10 Ea
SKU/REF 232208
-
BD Sensi-Disc™ Ertapenem ETP-10, 10 Ea
SKU/REF 232175
-
BD Sensi-Disc™ Ertapenem ETP-10, 1 Ea
SKU/REF 232174
-
Disc Cefixime Cfm-10 10 Ea
SKU/REF 232150
-
Disc Norfloxacin Nor-2 Belgium
SKU/REF 232102
-
BD BBL™ Sensi-Disc™ Tigecycline TGC-15, 1 Ea
SKU/REF 232087
-
BD BBL™ Sensi-Disc™ Linezolid LZD-30, 10 Ea
SKU/REF 231762
-
BD BBL™ Sensi-Disc™ Linezolid LZD-30, 1 Ea
SKU/REF 231761
-
BD BBL™ Sensi-Disc™ Moxifloxacin MXF-5, 10 Ea
SKU/REF 231758
-
BD BBL™ Sensi-Disc™ Fosfomycin FOS-200, 10 Ea
SKU/REF 231755
-
Disc Fosfomycin Fos-200
SKU/REF 231709
-
BD Sensi-Disc™ Levofloxacin LVX-5, 10 Ea
SKU/REF 231706
-
BD Sensi-Disc™ Levofloxacin LVX-5, 1 Ea
SKU/REF 231705
-
BD Sensi-Disc™ Meropenem MEM-10, 10 Ea
SKU/REF 231704
-
BD Sensi-Disc™ Meropenem MEM-10, 1 Ea
SKU/REF 231703
-
BD Sensi-Disc™ Cefepime FEP-30, 10 Ea
SKU/REF 231696
-
BD Sensi-Disc™ Gentamicin GM-120, 1 Ea
SKU/REF 231693
-
BD Sensi-Disc™ Piperacillin/Tazobactam TZP-110, 10 Ea
SKU/REF 231692
-
BD Sensi-Disc™ Piperacillin/Tazobactam TZP-110, 1 Ea
SKU/REF 231691
-
BD Sensi-Disc™ Azithromycin AZM-15, 10 Ea
SKU/REF 231682
-
BD Sensi-Disc™ Clarithromycin CLR-15, 10 Ea
SKU/REF 231678
-
BD Sensi-Disc™ Cefpodoxime CPD-10, 10 Ea
SKU/REF 231674
-
BD Sensi-Disc™ Cefpodoxime CPD-10, 1 Ea
SKU/REF 231673
-
BD Sensi-Disc™ Ofloxacin OFX-5, 10 Ea
SKU/REF 231672
-
BD Sensi-Disc™ Cefmetazole CMZ-30, 10 Ea
SKU/REF 231666
-
BD BBL™ Sensi-Disc™ Cefixime CFM-5, 10 Ea
SKU/REF 231664
-
BD BBL™ Sensi-Disc™ Ampicillin with Sulbactam SAM-20, 10 Ea
SKU/REF 231660
-
BD BBL™ Sensi-Disc™ Ciprofloxacin CIP-5, 10 Ea
SKU/REF 231658
-
BD BBL™ Sensi-Disc™ Ciprofloxacin CIP-5, 1 Ea
SKU/REF 231657
-
BD BBL™ Sensi-Disc™ Cefaclor CEC-30, 10 Ea
SKU/REF 231653
-
BD BBL™ Sensi-Disc™ Norfloxacin NOR-10, 10 Ea
SKU/REF 231647
-
BD BBL™ Sensi-Disc™ Imipenem IPM-10, 10 Ea
SKU/REF 231645
-
BD BBL™ Sensi-Disc™ Imipenem IPM-10, 1 Ea
SKU/REF 231644
-
BD BBL™ Sensi-Disc™ Aztreonam ATM-30, 10 Ea
SKU/REF 231641
-
BD BBL™ Sensi-Disc™ Aztreonam ATM-30, 1 Ea
SKU/REF 231640
-
BD Sensi-Disc™ Spectinomycin SPT-100, 10 Ea
SKU/REF 231637
-
BD BBL™ Sensi-Disc™ Ceftriaxone CRO-30, 10 Ea
SKU/REF 231635
-
BD BBL™ Sensi-Disc™ Ceftriaxone CRO-30, 1 Ea
SKU/REF 231634
-
BD BBL™ Sensi-Disc™ Ceftazidime CAZ-30, 10 Ea
SKU/REF 231633
-
BD BBL™ Sensi-Disc™ Ceftazidime CAZ-30, 1 Ea
SKU/REF 231632
-
Disc Amoxocillin Clavulanic Amc-30 1 Ea
SKU/REF 231628
-
BD Sensi-Disc™ Ceftizoxime ZOX-30, 10 Ea
SKU/REF 231623
-
BD Sensi-Disc™ Cefuroxime CXM-30, 10 Ea
SKU/REF 231621
-
BD Sensi-Disc™ Ticarcillin TIC-75, 10 Ea
SKU/REF 231619
-
BD BBL™ Sensi-Disc™ Cefoperazone CFP-75, 10 Ea
SKU/REF 231613
-
BD BBL™ Sensi-Disc™ Moxalactam MOX-30, 10 Ea
SKU/REF 231611
-
BD BBL™ Sensi-Disc™ Piperacillin PIP-100, 10 Ea
SKU/REF 231609
-
BD BBL™ Sensi-Disc™ Piperacillin PIP-100, 1 Ea
SKU/REF 231608
-
BD BBL™ Sensi-Disc™ Cefotaxime CTX-30, 10 Ea
SKU/REF 231607
-
BD BBL™ Sensi-Disc™ Cefotaxime CTX-30, 1 Ea
SKU/REF 231606
-
BD BBL™Sensi-Disc™ Metronidazole MET-80, 10 Ea
SKU/REF 231605
-
BD BBL™ Sensi-Disc™ Netilmicin NET-30, 10 Ea
SKU/REF 231603
-
BD BBL™ Sensi-Disc™ Trimethoprim TMP-5, 10 Ea
SKU/REF 231601
-
BD BBL™ Sensi-Disc™ Cinoxacin CIN-100, 10 Ea
SKU/REF 231599
-
BD BBL™ Sensi-Disc™ Amikacin AN-30, 10 Ea
SKU/REF 231597
-
BD BBL™ Sensi-Disc™ Cefazolin CZ-30, 10 Ea
SKU/REF 231593
-
BD BBL™ Sensi-Disc™ Cefoxitin FOX-30, 10 Ea
SKU/REF 231591
-
BD BBL™ Sensi-Disc™ Cefoxitin FOX-30, 1 Ea
SKU/REF 231590
-
BD BBL™ Sensi-Disc™ Tobramycin NN-10, 10 Ea
SKU/REF 231569
-
BD BBL™ Sensi-Disc™ Tobramycin NN-10, 1 Ea
SKU/REF 231568
-
BD BBL™ Sensi-Disc™ Rifampin RA-5, 10 Ea
SKU/REF 231544
-
BD BBL™ Sensi-Disc™ Rifampin RA-5, 1 Ea
SKU/REF 231541
-
Disc Vancomycin Va-30 10 Ea
SKU/REF 231353
-
Disc Vancomycin Va-5 10 Ea
SKU/REF 231352
-
Disc Tetracycline Te-30 10 Ea
SKU/REF 231344
-
BD Sensi-Disc™ Oxytetracycline T-30, 10 Ea
SKU/REF 231342
-
Disc Streptomycin S-10 10 Ea
SKU/REF 231328
-
BD Sensi-Disc™ Polymyxin B PB-300, 10 Ea
SKU/REF 231324
-
BD Sensi-Disc™ Penicillin P-10, 10 Ea
SKU/REF 231321
-
Disc Oxacillin Ox-1 10 Ea
SKU/REF 231319
-
BD Sensi-Disc™ Novobiocin NB-30, 10 Ea
SKU/REF 231315
-
Disc Novobiocin Nb-5 10 Ea
SKU/REF 231314
-
BD Sensi-Disc™ Neomycin N-30, 10 Ea
SKU/REF 231313
-
Disc Nalidixic Acid Na-30 10 Ea
SKU/REF 231311
-
BD Sensi-Disc™ Kanamycin K-30, 10 Ea
SKU/REF 231301
-
Disc Gentamicin Gm-10 10 Ea
SKU/REF 231299
-
Disc Nitrofurantoin F/M-300 10 Ea
SKU/REF 231293
-
BD Sensi-Disc™ Nitrofurantoin F/M-100, 10 Ea
SKU/REF 231292
-
Disc Erythromycin E-15 10 Ea
SKU/REF 231290
-
Disc Erythromycin E2 10 Ea
SKU/REF 231289
-
BD Sensi-Disc™ Doxycycline D-30, 10 Ea
SKU/REF 231286
-
Disc Colistin Cl-10 10 Ea
SKU/REF 231278
-
Disc Clindamycin Cc-2 10 Ea
SKU/REF 231275
-
Disc Chloramphenicol C-30 10 Ea
SKU/REF 231274
-
Disc Cephalothin Cf-30 10 Ea
SKU/REF 231271
-
BD Sensi-Disc™ Bacitracin B-10, 10 Ea
SKU/REF 231268
-
BD Sensi-Disc™ Bacitracin B-2, 10 Ea
SKU/REF 231267
-
BD BBL™ Sensi-Disc™ Ampicillin AM-10, 10 Ea
SKU/REF 231264
-
BD BBL™ Sensi-Disc™ Minocycline MIN-30, 10 Ea
SKU/REF 231251
-
BD BBL™ Sensi-Disc™ Minocycline MIN-30, 1 Ea
SKU/REF 231250
-
BD BBL™ Sensi-Disc™ Gentamicin GM-10, 1 Ea
SKU/REF 231227
-
BD BBL™ Sensi-Disc™ Clindamycin CC-2, 1 Ea
SKU/REF 231213
-
BD BBL™ Sensi-Disc™ Nitrofurantoin F/M-300, 1 Ea
SKU/REF 231149
-
BD BBL™ Sensi-Disc™ Vancomycin VA-30, 1 Ea
SKU/REF 231034
-
BD BBL™ Sensi-Disc™ Vancomycin VA-5, 1 Ea
SKU/REF 231030
-
BD BBL™ Sensi-Disc™ Tetracycline Te-30, 1 Ea
SKU/REF 230998
-
BD BBL™ Sensi-Disc™ Streptomycin S-10, 1 Ea
SKU/REF 230942
-
BD BBL™ Sensi-Disc™ Penicillin P-10, 1 Ea
SKU/REF 230918
-
BD BBL™ Sensi-Disc™ Oxacillin OX-1, 1 Ea
SKU/REF 230906
-
BD BBL™ Sensi-Disc™ Novobiocin NB-5, 1 Ea
SKU/REF 230886
-
BD BBL™ Sensi-Disc™ Nalidixic Acid NA-30, 1 Ea
SKU/REF 230874
-
BD Sensi-Disc™ Furazolidone FX-100, 1 Ea
SKU/REF 230809
-
BD BBL™ Sensi-Disc™ Erythromycin E-15, 1 Ea
SKU/REF 230793
-
BD BBL™ Sensi-Disc™ Colistin CL-10, 1 Ea
SKU/REF 230749
-
BD BBL™ Sensi-Disc™ Chloramphenicol C-30, 1 Ea
SKU/REF 230733
-
BD BBL™ Sensi-Disc™ Cephalothin CF-30, 1 Ea
SKU/REF 230725
-
BD BBL™ Sensi-Disc™ Ampicillin AM-10, 1 Ea
SKU/REF 230705
BD BBL™ Sensi-Disc™ antimicrobial susceptibility test discs
Achieve accurate, reliable, and convenient disc diffusion for antimicrobial susceptibility testing (AST) with our comprehensive portfolio of 110+ products.

- Overview
- Products & Accessories
- EIFU & Resources
- FAQ
Accurate and timely diagnosis can enable clinicians to make informed decisions, so they can help guide treatment for their patients. The BD BBL™ Sensi-Disc™ portfolio provides labs with an accurate, convenient, and broad range of disk diffusion solutions. One of the latest additions to our FDA-approved disk diffusion test portfolio is the Cefiderocol 30µg disc (232255).
BD’s stringent quality standards and experience in disc development and manufacturing results in discs that produce accurate and consistent results.
Comprehensive portfolio
To help address your emerging ID/AST needs, we continue to evolve our broad disk diffusion portfolio of +110 products.1 Our recent addition, the Cefiderocol 30µg disc can be used to determine susceptibility to Cefiderocol against bacteria for complicated urinary tract infections (cUTIs), hospital-acquired bacterial pneumonia and ventilator-associated bacterial pneumonia.1
Aligned with standards
The drug content of our discs is assayed by the methods established by the FDA,1 and is the concentration recommended for AST by the Clinical and Laboratory Standards Institute (CLSI).2 Labs can confidently use them to standardize testing by the Kirby-Bauer disk diffusion method adopted as the consensus standard by CLSI.1 This procedure is also accepted by both the FDA3 and the WHO.4,5
Consistency
BD BBL™ Sensi-Disc™ test discs are 6-mm each and contain accurately determined amounts of antibiotic or other chemotherapeutic agents. Each disc is clearly marked on both sides with letters and numbers designating the agent and the drug content.1
Cost effective
BD BBL™ Sensi-Disc™ disc diffusion products offer an effective and more likely economical alternative for AST. Using our wide range of discs, you can enable versatile testing throughout your facility from one trusted source.
FDA: U.S. Food and Drug Administration; CLSI: Clinical Laboratory Standards Institute; WHO: World Health Organization
1. Cefiderocol IFU
2. Humphries, R. Differences in Disk Content Recommended by CLSI and EUCAST for Disk Diffusion Testing. 2019. CLSI and EUCAST recommendations for Disk Diffusion Testing
3. Clinical and Laboratory Standards Institute (formerly National Committee for Clinical Laboratory Standards). 2003. Approved standard M02 Ed 2018. Performance standards for antimicrobial disk susceptibility tests, 13th ed. NCCLS, Wayne, PA.
4. Federal Register. 1972. Rules and regulations. Antibiotic susceptibility discs. Fed. Regist. 37: 20525-20529. Erratum, 38: 2756, 1973.
5. Ericsson, H.M., and J.C. Sherris. 1971. Antibiotic sensitivity testing. Report of an international collaborative study. Acta Pathol Microbiol Scand. Sec. B. Suppl. 217: 1-90.
6. World Health Organization Expert Committee on Biological Standardization. 1977. Technical report series 610. W.H.O., Geneva.
1. Ahman J, et al., The quality of antimicrobial discs from nine manufacturers- EUCAST evaluations in 2014 and 2017, Clinical Microbiology and Infection(2018), https://doi.org/10.1016/j.cmi.2018.05.021.
Our collection of literature on industries and on our offerings gives you information you can use to continue striving for excellence.
1. Ahman J, et al., The quality of antimicrobial discs from nine manufacturers- EUCAST evaluations in 2014 and 2017, Clinical Microbiology and Infection(2018), https://doi.org/10.1016/j.cmi.2018.05.021.


